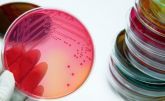

3/2014 (51) июль-сентябрь
- Квартальные события
- Конференция «Обеспечение качества лекарственных средств 2014» – международная, пятая, юбилейная

Середина июня - традиционно, пятый год подряд, вовлекает специалистов фармацевтических предприятий в мир обеспечения качества лекарственных средств. 16-19 июня текущего года в г. Минске состоялась пятая международная конференция «Обеспечение качества лекарственных средств 2014».
- Российская неделя валидации

С 1 по 5 декабря 2014 года в Москве начнется первая Российская неделя валидации. Это больше, чем модульный семинар, больше чем хорошее обучение. Это лучшая программа профессионального развития специалистов, занимающихся валидацией. Время теории прошло!
- Чистые помещения
- Совершенствование стандарта по биозагрязнениям

Статья публикуется с разрешения редакции журнала Cleanroom Technology, апрель 2014 (www.cleanroom-technology.co.uk)
- Стандарты строительных работ: снижение риска загрязнения в условиях проведения операций

Материал к публикации подготовлен специалистами компании ООО «УНИКА Инжиниринг»
- Системы мониторинга чистых помещений: краткое руководство по внедрению

Для обеспечения соответствия производственных сред рекомендациям GМР все чаще и чаще используются специализированные системы мониторинга. Матиас Албер шаг за шагом рассматривает этапы планирования и внедрения такой системы
- Планирование модернизации объекта без прерывания производства

Статья публикуется с разрешения редакции журнала Cleanroom Technology, апрель 2013 (www.cleanroom-technology.com.uk)
- Определение требований к оборудованию для пылевого контроля

Статья публикуется с разрешения редакции журнала Qeanroom Technology, февраль 2014 (www.cleanroom-technology.co.uk)
Эффективный пылевой контроль и изоляция обрабатываемых компонентов являются ключевыми требованиями фармацевтического предприятия.
- Рекомендации PIC/S «Приложение 1 к GMP в редакции 2008 г. Интерпретация наиболее важных изменений по производству стерильных лекарственных средств»

Pharmaceutical inspection convention, pharmaceutical inspection co-operation scheme (http://www.picscheme.org)
- Технологические среды
- Выбор конструкционного материала и способа санитарной обработки системы распределения воды фармацевтического качества

На стадии проектирования и реализации систем получения воды очищенной (ВО) и воды для инъекций (ВДИ) регулярно встает вопрос о конструкционном материале системы распределения. В последнее время в результате постепенного внедрения надлежащей инженерной практики GEP) и принципов GMP список используемых материалов существенно сократился.
- Чистый барьер
- Разработка тканей, снижающих распространение вирусов
Учёные из Hohenstein Institute (Германия) впервые разработали ткань, сочетающую антивирусные и антибактериальные свойства
- Прерывание цепной передачи инфекции

Статья публикуется с разрешения редакции журнала Cleanroom Technology, май 2013 (www.cleanroom-technology.co.uk
Одежда медицинских работников является одним из ключевых факторов, способствующих прерыванию цепной передачи инфекции. Сотрудники Института Хоенштайн тщательно изучили эту проблему и пути ее решения
- Единое технологическое решение для изготовления асептических и высокоактивных препаратов

Статья публикуется с разрешения редакции журнала Cleanroom Technology, февраль 2014 (www.deanroom-technology.co.uk)
В этой статье представлены некоторые проблемы, связанным с оборудованием для производства асептических и высокоактивных препаратов, а также пути их возможного решения
- Инженерная практика
- Воздействие физико-химических свойств АФС на разработку метода и валидацию очистки

Статья опубликована на сайте www.ivtnetwork.com
- «GMP за недорого!»

Выступление на конференции «Обеспечение качества лекарственных средств 2014»













